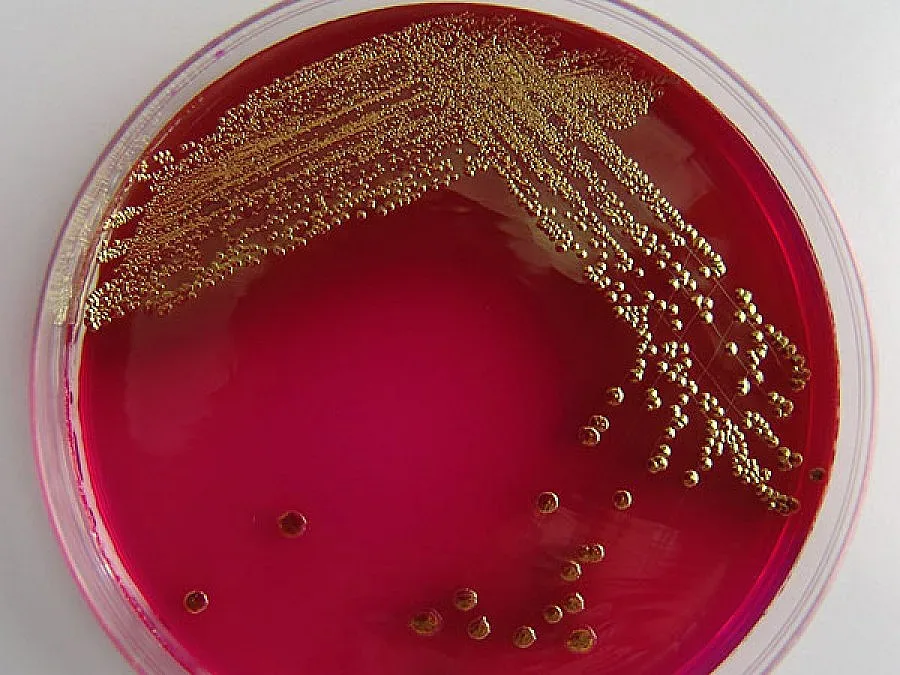
Туршия с Ешерихия коли уби шестима

Токио. Шестима души починаха в Северна Япония след като са консумирали туршия, заразена с бактерията Ешерихия коли, като това е най-смъртоносното масово натравяне с храна в страната през последните десет години, съобщиха японските власти, цитирани от АФП.
Още 103 души са заболели след като са яли от същото леко мариновано китайско зеле, произведено в края на юли от компания в град Сапоро. От починалите петима са били възрастни хора, които са консумирали туршията в частни клиники в Сапоро и още един град на остров Хокайдо. Също така е загинало четиригодишно момиче.
Последвайте ни в Google News Showcase за важните новини
Вижте всички актуални новини от Standartnews.com